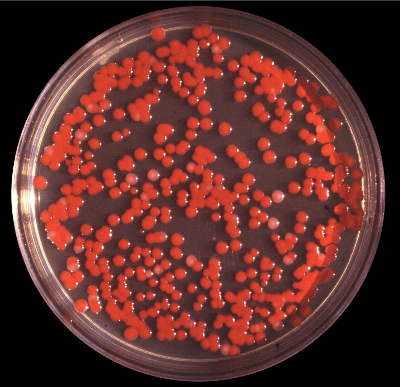
세라티아 마르세센스균

목차
1. 세라티아 마르세센스균이란
2. 세라티아 마르세센스균의 원인
3. 세라티아 마르세센스균의 특징
4. 물때 제거를 위한 청소 방법
5. 효과적인 소독 및 예방 방법
6. 자주 묻는 질문(FAQ)
세라티아 마르세센스균에 대해 많은 분들이 한 번쯤은 들어보셨을 것입니다. 이 균은 주로 욕실이나 화장실 같은 습기 있는 곳에서 쉽게 발견되는 균으로, 분홍색 물때를 형성하는 주범이기도 합니다. 이번 포스팅에서는 세라티아 마르세센스균의 원인과 효과적인 제거 방법에 대해 자세히 알아보도록 하겠습니다.

1. 세라티아 마르세센스균이란
세라티아 마르세센스균(Serratia marcescens)은 그람 음성균으로, 일반적으로 습기 있는 곳에서 자주 발견됩니다. 이 균은 보통 붉은색 또는 분홍색으로 물때를 형성하며, 주로 욕실의 타일, 변기, 세면대 등에서 자주 볼 수 있습니다. 이 균은 감염의 원인이 될 수 있으므로 주의가 필요합니다.
2. 세라티아 마르세센스균의 원인
세라티아 마르세센스균은 주로 다음과 같은 원인으로 발생합니다.
- 습기 : 욕실과 화장실은 습기가 많아 균이 자생하기 좋은 환경을 제공합니다.
- 온도 : 따뜻한 온도는 균의 생장에 유리합니다. 특히 겨울철 난방이 들어오면 더욱 쉽게 발생할 수 있습니다.
- 유기물 : 비누 찌꺼기, 각질 등 유기물이 쌓이면 세라티아 마르세센스균의 번식을 촉진합니다.
3. 세라티아 마르세센스균의 특징
세라티아 마르세센스균은 일반적으로 다음과 같은 특징을 가지고 있습니다.
- 형태 : 둥글고 작은 콜로니 형태로 자생하며, 이들이 모여 분홍색 물때를 형성합니다.
- 저항성 : 여러 가지 환경적 요인에도 잘 견디며, 일반적인 세척제로는 쉽게 제거되지 않는 경우가 많습니다.
4. 물때 제거를 위한 청소 방법
효과적으로 세라티아 마르세센스균을 제거하기 위해서는 다음과 같은 방법을 따르는 것이 좋습니다.
- 청소 도구 준비 : 스펀지, 브러시, 세제, 물 등이 필요합니다.
- 세척제 사용 : 일반적인 세제를 사용하거나 클로르계 표백제를 사용하는 것이 효과적입니다. 특히, 산화력이 강한 세제가 좋습니다.
- 부드럽게 문지르기 : 물때가 있는 부분을 부드럽게 문질러 주며, 특히 모서리나 틈새 부분은 잘 청소해 주어야 합니다.
- 철저한 헹굼 : 세척 후 충분히 헹구어 잔여물을 제거하는 것이 중요합니다.
- 예방조치 : 청소 후에는 꼭 건조시켜 주어야 하며, 주기적으로 청소하는 습관을 기르는 것이 좋습니다.
5. 효과적인 소독 및 예방 방법
세라티아 마르세센스균의 재발을 방지하기 위해 다음과 같은 방법들을 참고해 보세요.
- 정기적인 청소 : 일주일에 한 번 이상 청소하는 것이 좋습니다.
- 환기 : 욕실 환기를 잘 해주어 습도를 낮추는 것이 중요합니다.
- 소독제 사용 : 세척 후 소독제를 사용하여 균을 완전히 제거하는 것도 좋은 방법입니다.
- 물기 제거 : 세면대와 바닥의 물기를 항상 제거해 주는 것이 좋습니다.
6. 자주 묻는 질문(FAQ)
- 세라티아 마르세센스균은 인체에 해로운가요?
세라티아 마르세센스균은 일반적으로 건강한 사람에게는 큰 문제가 되지 않지만, 면역력이 약한 사람에게는 감염을 일으킬 수 있습니다.
- 어떻게 예방할 수 있나요?
정기적인 청소와 환기, 그리고 물기 제거가 가장 효과적인 예방 방법입니다.
세라티아 마르세센스균은 관리만 잘해주면 충분히 예방할 수 있는 균입니다. 주기적인 청소와 예방 조치를 통해 깨끗한 화장실을 유지하시기 바랍니다.
[건강 정보] - 스위치온 다이어트 식단 및 단백질 셰이크 추천
스위치온 다이어트 식단 및 단백질 셰이크 추천
하늘은 높고 말은 살이 찐다는 천고마비의 계절 가을입니다.추운 겨울을 대비하기 위해 우리 몸은 가을부터 체지방을 축적하려고 합니다.더 추워지기 전에 몸에 좋은 제철음식으로 스위치온 다
moms-dream.com
[건강 정보] - 내 몸 속 쌓인 독소 배출과 소화에 좋은 식사 법
내 몸 속 쌓인 독소 배출과 소화에 좋은 식사 법
우리 몸은 해독과 영양의 작용이 늘 이루어지고 있습니다. 하루 이틀 가공식품을 먹는다고 해서 바로 우리 몸에 이상이 생기지 않는 것입니다. 우리가 쉽게 접할 수 있는 가공식품은 독을 먹는
moms-dream.com